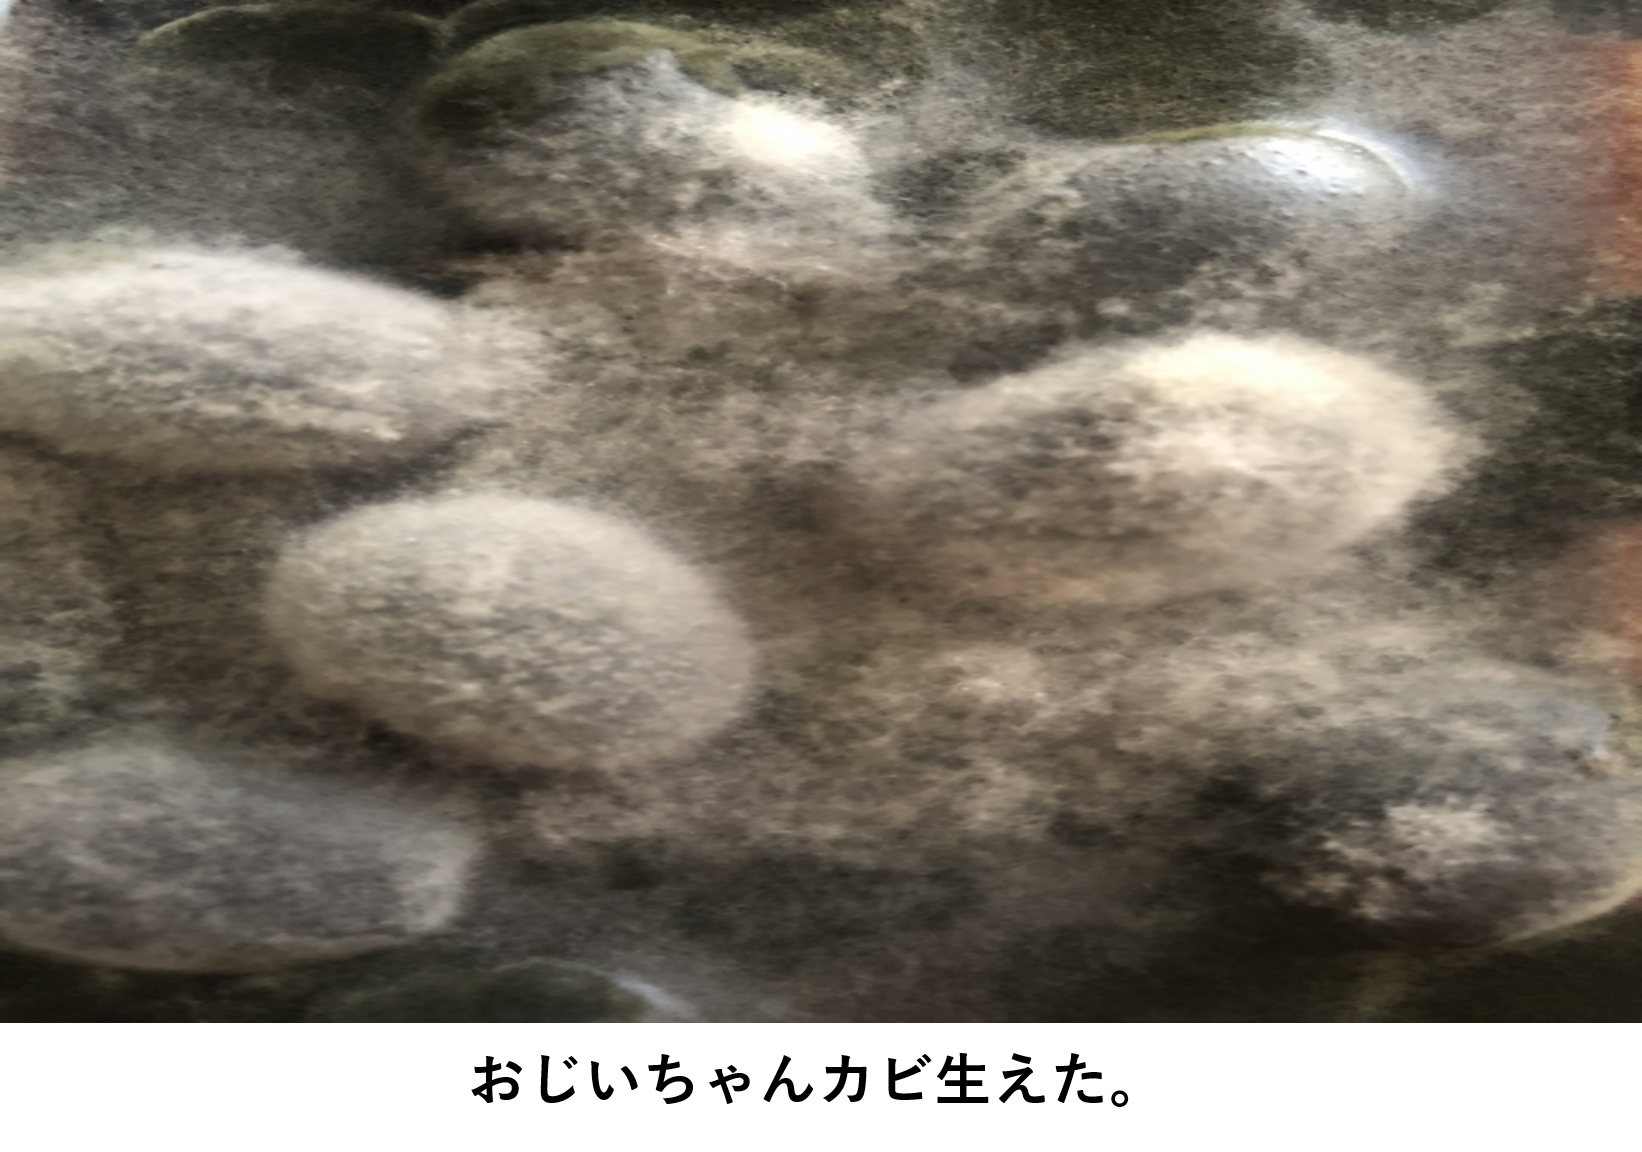

Sponsored Link
食品添加物、保存料、防かび剤、殺菌料、酸化防止剤、発色剤、色調調整剤、着色料、甘味料の覚え方
前回の食品の変色と発がん性物質、メイラード反応などのまとめでは食品の変色などを見ました。実際の食品では、食品が変色したりするのを防ぐために食品添加物などが使われていることがあります。今回は食品添加物について見ていきます。今回ゴロ多めです(笑)

まず食品添加物は、食品の製造の過程において又は食品の加工もしくは保存の目的で、食品に使用するものと定義されています。「食品添加物を使用しておりません」などとアピールする企業があるように、食品添加物は使い過ぎも問題となります。そのため食品衛生法で規制を受けています。食品衛生法における食品添加物は
- 指定添加物;厚生労働大臣が指定した添加物
- 既存添加物;長年使用されてきた添加物
- 天然香料;食品に香りをつける目的で使用される天然の物質。
- 一般飲食添加物;一般には食品だが、添加物として使用されるもの
などがあります。指定添加物や既存添加物は規制の対象となり指定制度がとられています。食品衛生法の指定制度は、ポジティブリスト方式とも呼ばれ安全性・有効性の両方が確認された食品添加物だけ使用許可が出るようになっています。
食品添加物は使用された添加物は原則表示しなければなりませんが、以下の場合は表示が免除されています。
- 加工助剤;最終的に食品中にごくわずかな量しか存在せず、食品に影響を及ぼさない食品添加物
- キャリーオーバー;食品の原材料の製造などに使用される食品添加物
- 栄養強化剤;ビタミンなど栄養強化の目的で使用される食品添加物
これらの食品添加物のルールを守るように各製造施設ごとに食品衛生管理者の設置が義務付けられています。
食品添加物の種類には以下のようなものがあります。
- 保存料
- 防かび剤
- 殺菌料
- 酸化防止剤
- 発色剤
- 色調調整剤
- 着色料
- 甘味料
Sponsored Link
Sponsored Link
保存料
保存料は食品中の微生物の増殖を抑えることで腐敗を防ぎます。保存料は以下のようなものがあります。
- プロピオン酸
- パラオキシ安息香酸エステル類
- ソルビン酸
- デヒドロ酢酸ナトリウム
- 安息香酸
プロピオン酸、ソルビン酸、安息香酸などは酸型保存料であり、酸性条件下で効果が大きくなります。それに対して、パラオキシ安息香酸エステル類はエステルであるためpHの影響を受けにくいです。保存料はゴロを使って覚えましょう。
- 保存するフロッピー、パラソルで安心

- 保存;保存料
- フロッピー;プロピオン酸
- パラ;パラオキシ安息香酸エステル類
- ソル;ソルビン酸
- で;デヒドロ酢酸ナトリウム
- 安心;安息香酸
イメージ作りの物語を。ある機密情報が入っているフロッピー。濡らしてしまうとデータが破損してしまう可能性があります。しかし、傘(パラソル)で雨を防げば安心という内容です。最近はフロッピーも死語となりましたね(笑)
防かび剤
防かび剤は柑橘類などのかびが生えるのを防ぎます。アメリカなどでは収穫後に使用される農薬として使われます。防かび剤には以下のようなものがあります。
- オルトフェニルフェノール
- ジフェニル
- イマザリル
- チアベンダゾール
防かび剤もゴロを使って覚えましょう。
- おじいちゃんカビ生えた。
- お;オルトフェニルフェノール
- じ;ジフェニル
- い;イマザリル
- ちゃん;チアベンダゾール
- カビ;防かび剤
イメージ作りの物語を語るまでもないですが、何年も風呂に入っていなかったおじいちゃんにカビが生えてしまったのをイメージしましょう(笑)
殺菌料
保存料は殺菌作用はありませんでしたが、殺菌料は殺菌作用があります。殺菌料には以下のようなものがあります。
- 次亜塩素酸ナトリウム
- 過酸化水素
殺菌料のゴロです。
- ジャイア〇、母さん殺した

- ジャイアン〇;次亜塩素酸ナトリウム
- 母さん;過酸化水素
- 殺した;殺菌料
イメージ作りの物語を。ジャイア〇はのび〇などをボコボコにして、ガキ大将の地位を確立していますが、唯一の弱点が母さんです。しかし、ある時ジャイア〇が逆切れして母さんを殺してしまったという話です。
酸化防止剤
酸化防止剤は、色素の変色や油脂の酸化を防ぎます。酸化防止剤にはラジカル捕捉剤、還元剤、キレート剤などの種類があり、以下のようなものがあります。
ラジカル捕捉剤
- dl-α-トコフェロール
- BHA(ブチルヒドロキシアニソール)
- BHT(ジブチルヒドロキシトルエン)
- 没食子酸プロピル
還元剤
- エリソルビン酸
- L-アスコルビン酸
キレート剤
- クエン酸イソプロピル
- エチレンジアミン四酢酸二ナトリウム
脂質の変敗で確認したように、油脂の酸化にはラジカルが関わります。ラジカル捕捉剤はペルオキシラジカルに水素を与えて、自身が酸化されることによって油脂の参加を防ぎます。ラジカル捕捉剤は脂溶性です。
ラジカル捕捉剤に対して還元剤は水溶性です。
これも強引ですが、国試勉強時代にゴロを教わったので一応載せておきます。
- 所沢が油で火事だ!ボボボボーン!エリちゃんの明日からお水の仕事。「金くれぇ〜」

- 所沢;トコフェロール
- 油;脂溶性
- 火事;ラジカル
- ボ;BHA
- ボ;BHT
- ボ;没食子酸プロピル
- エリ;エリソルビン酸
- 明日;アスコルビン酸
- お水;水溶性
- 金;キレート
- く;クエン酸イソプロピル
- ぇ;エチレンジアミン四酢酸二ナトリウム
イメージ作りの物語です。所沢在住のエリちゃんがタバコの不始末で火事を起こしてしまいました。お金の無くなったエリちゃんは明日から水商売で稼いで返済していくしかありません。思わず「金くれぇ〜」と言っているお話です。
このゴロ長いうえに、明治薬科大学の方しかイメージできないと思います・・・(笑)
発色剤
発色剤は食肉などの色素と結合して色を安定化させます。発色剤には以下のようなものがあります。
- 亜硝酸ナトリウム
亜硝酸ナトリウムはNOを作り出し、ヘモグロビンなどとくっついて発色します。
色調調整剤
色調調整剤は野菜などのアントシアニンと錯体を作り色を安定化させます。色調調整剤には以下のようなものがあります。
- 硫酸第一鉄
一応ゴロを紹介しておきます。
- ベジタリアンなリュウさん

- ベジタリ;野菜
- アン;アントシアニン
- リュウさん;硫酸第一鉄
イメージ作りの物語を語るまでもないですが、波動拳で有名なリュウはマッチョです。しかし、実はベジタリアンだったという物語です。ちなみに私は波動拳のコマンド入力苦手でした。格ゲーのセンス無し(笑)
着色料
着色料は食品に色をつけます。着色料には以下のようなものがあります。
- β-カロテン
- 二酸化チタン
- クロロフィル
- ベンガラ
これらは非タール系と呼ばれる着色料です。タール系の着色料は青色1号などの「〇色△号」となっています。非タール系のゴロを載せておきます。
- 着火時黒色便

- 着;着色剤
- 火;カロテン
- 時;二酸化チタン
- 黒;クロロフィル
- 便;ベンガラ
これもイメージ作りの物語を語るまでもないですね。おしりに着火したら、驚いて黒色便が出てしまったというお話です。
甘味料
甘味料は砂糖の代替品として使われるため有名ですね。甘味料には以下のようなものがあります。
- サッカリン
- アスパルテーム
- キシリトール
- スクラロース
- アセスルファムカリウム
これらは有名なので、ゴロ無しでも覚えられると思います。国試では食品添加物とその代表例を選ぶ問題があるので、ゴロを使えるところは使って抑えましょう。
まとめ
- 食品添加物は食品の製造の過程において又は食品の加工もしくは保存の目的で、食品に使用するもの
- 食品添加物には、保存料、防かび剤、殺菌料、酸化防止剤、発色剤、色調調整剤、着色料、甘味料などがある。
- 食品添加物とその代表例を抑える。
